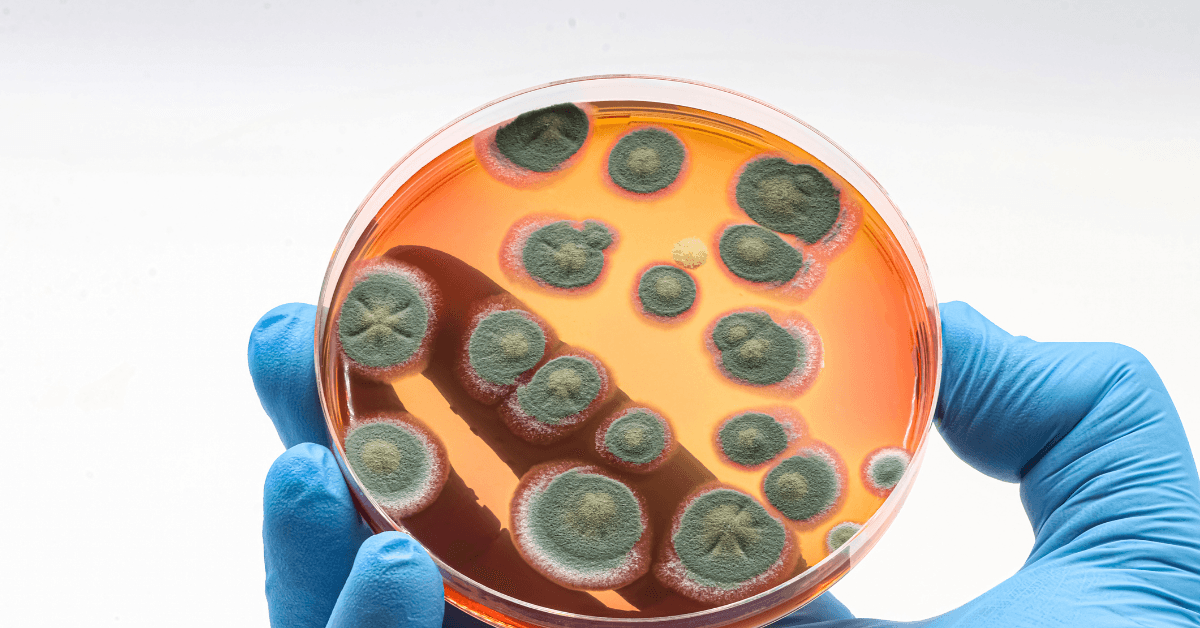
A gloved hand holding a petri dish filled with orange agar, displaying multiple circular green mold colonies of varying sizes across the surface.

This Special Issue will feature cutting-edge research on β-lactam antibiotics to commemorate 80 years since the Nobel Prize was awarded to this historic breakthrough in medicine. Submit your manuscript by June 30, 2026.
To commemorate the 80th anniversary of the Nobel Prize awarded for the discovery of β-lactam antibiotics, ACS Infectious Diseases is launching a Special Issue dedicated to the foundation of antibacterial therapy. β-Lactams revolutionized modern medicine by providing the first effective treatments for infections like pneumonia and sepsis, yet their clinical success has been continually challenged by evolving resistance mechanisms. This Special Issue aims to celebrate the legacy of β-lactams while driving forward innovation to ensure their continued relevance in modern medicine.
We invite submissions of original research articles, letters, and reviews on topics including β-lactam discovery and development, combination therapies, resistance mechanisms, PBP and β-lactamase structures, inhibitor design, nanotechnology-based delivery, synthetic biology, and AI-driven approaches. Manuscripts should be submitted by June 30, 2026.
Topics include, but are not limited to:
- β-Lactam discovery and development
- β-Lactam conjugates or combination therapies
- Chemistry, mechanism of action and structure–activity relationships
- Resistance mechanisms and combatting resistance
- PBP structure and function
- β-Lactamase structures and inhibitors
- Nanotechnology and delivery systems
- Synthetic biology approaches
- Artificial intelligence in designing β-lactam antibiotics and inhibitors
Submit your manuscript by June 30, 2026.
Organizing Editors
Jayanta Haldar, Editor-in-Chief, ACS Infectious Diseases
Jawaharlal Nehru Centre for Advanced Scientific Research (JNCASR), India
Shahriar Mobashery, Editorial Advisory Board, ACS Infectious Diseases
University of Notre Dame, United States
Submission Information
We welcome submissions for this Special Issue through June 30, 2026. For more information on submission requirements, please visit the journal’s Author Guidelines page.
Accepted manuscripts for consideration in this Special Issue will include research articles, letters, reviews, and perspectives and viewpoints (the two latter by invitation only). Papers accepted for publication for this Special Issue will be available ASAP (as soon as publishable) online. After all submissions have been published, they will then be compiled online on a dedicated landing page to form the Special Issue. Manuscripts submitted for consideration will undergo the full rigorous peer review process expected from ACS journals.
Open Access: There are diverse open access options for publications in American Chemical Society journals. Please visit our Open Science Resource Center for more information.
How to Submit
- Log in to the ACS Publishing Center.
- Select the "Journals" tab.
- Choose ACS Infectious Diseases.
- Click "Submit."
- Select your manuscript type, and, under "Special Issue Selection," choose “Celebrating 80 years of the β-lactam Nobel Prize."
If you have any general questions regarding submission to this Special Issue, please contact eic@id.acs.org.

Stay Connected with ACS Infectious Diseases
